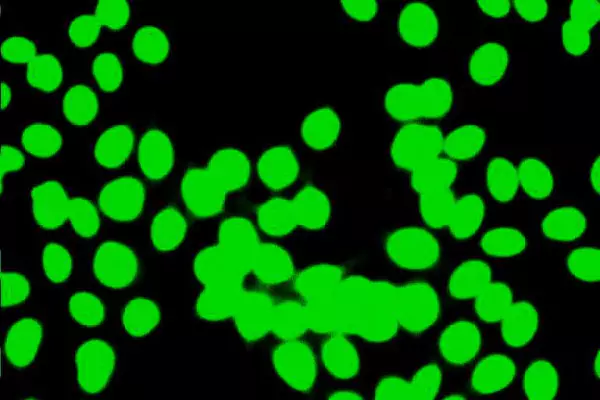

- Empty cart.
- Continue Shopping

₹2,400.00
Add to cartANA By IF With Titer
₹2,400.00
Add to cart
Buy Now
-
Ask a Question
Ask a Question

ANA By IF With Titer
₹2,400.00
Category: SPECIAL TEST
Guaranteed Safe Checkout
Free
Worldwide Shopping
100%
Guaranteed Satisfaction
30 Day
Guaranteed Money Back
Be the first to review “ANA By IF With Titer” Cancel reply

Reviews
There are no reviews yet.